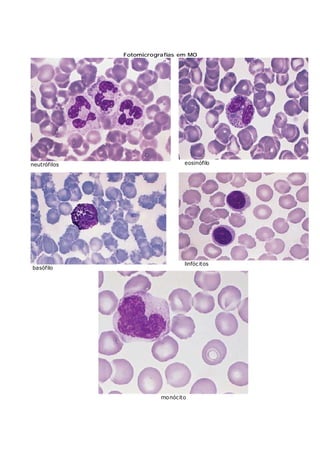
Fotomicrografias em MO
neutrófilos eosinófilo
basófilo
linfócitos
monócito

O documento resume os principais componentes do sangue humano, incluindo plasma, eritrócitos, leucócitos e plaquetas. Detalha o processo de hematopoiese na medula óssea, onde as células-tronco dão origem às células sanguíneas através da influência de fatores de crescimento. Também descreve defeitos como anemia e hemofilia.